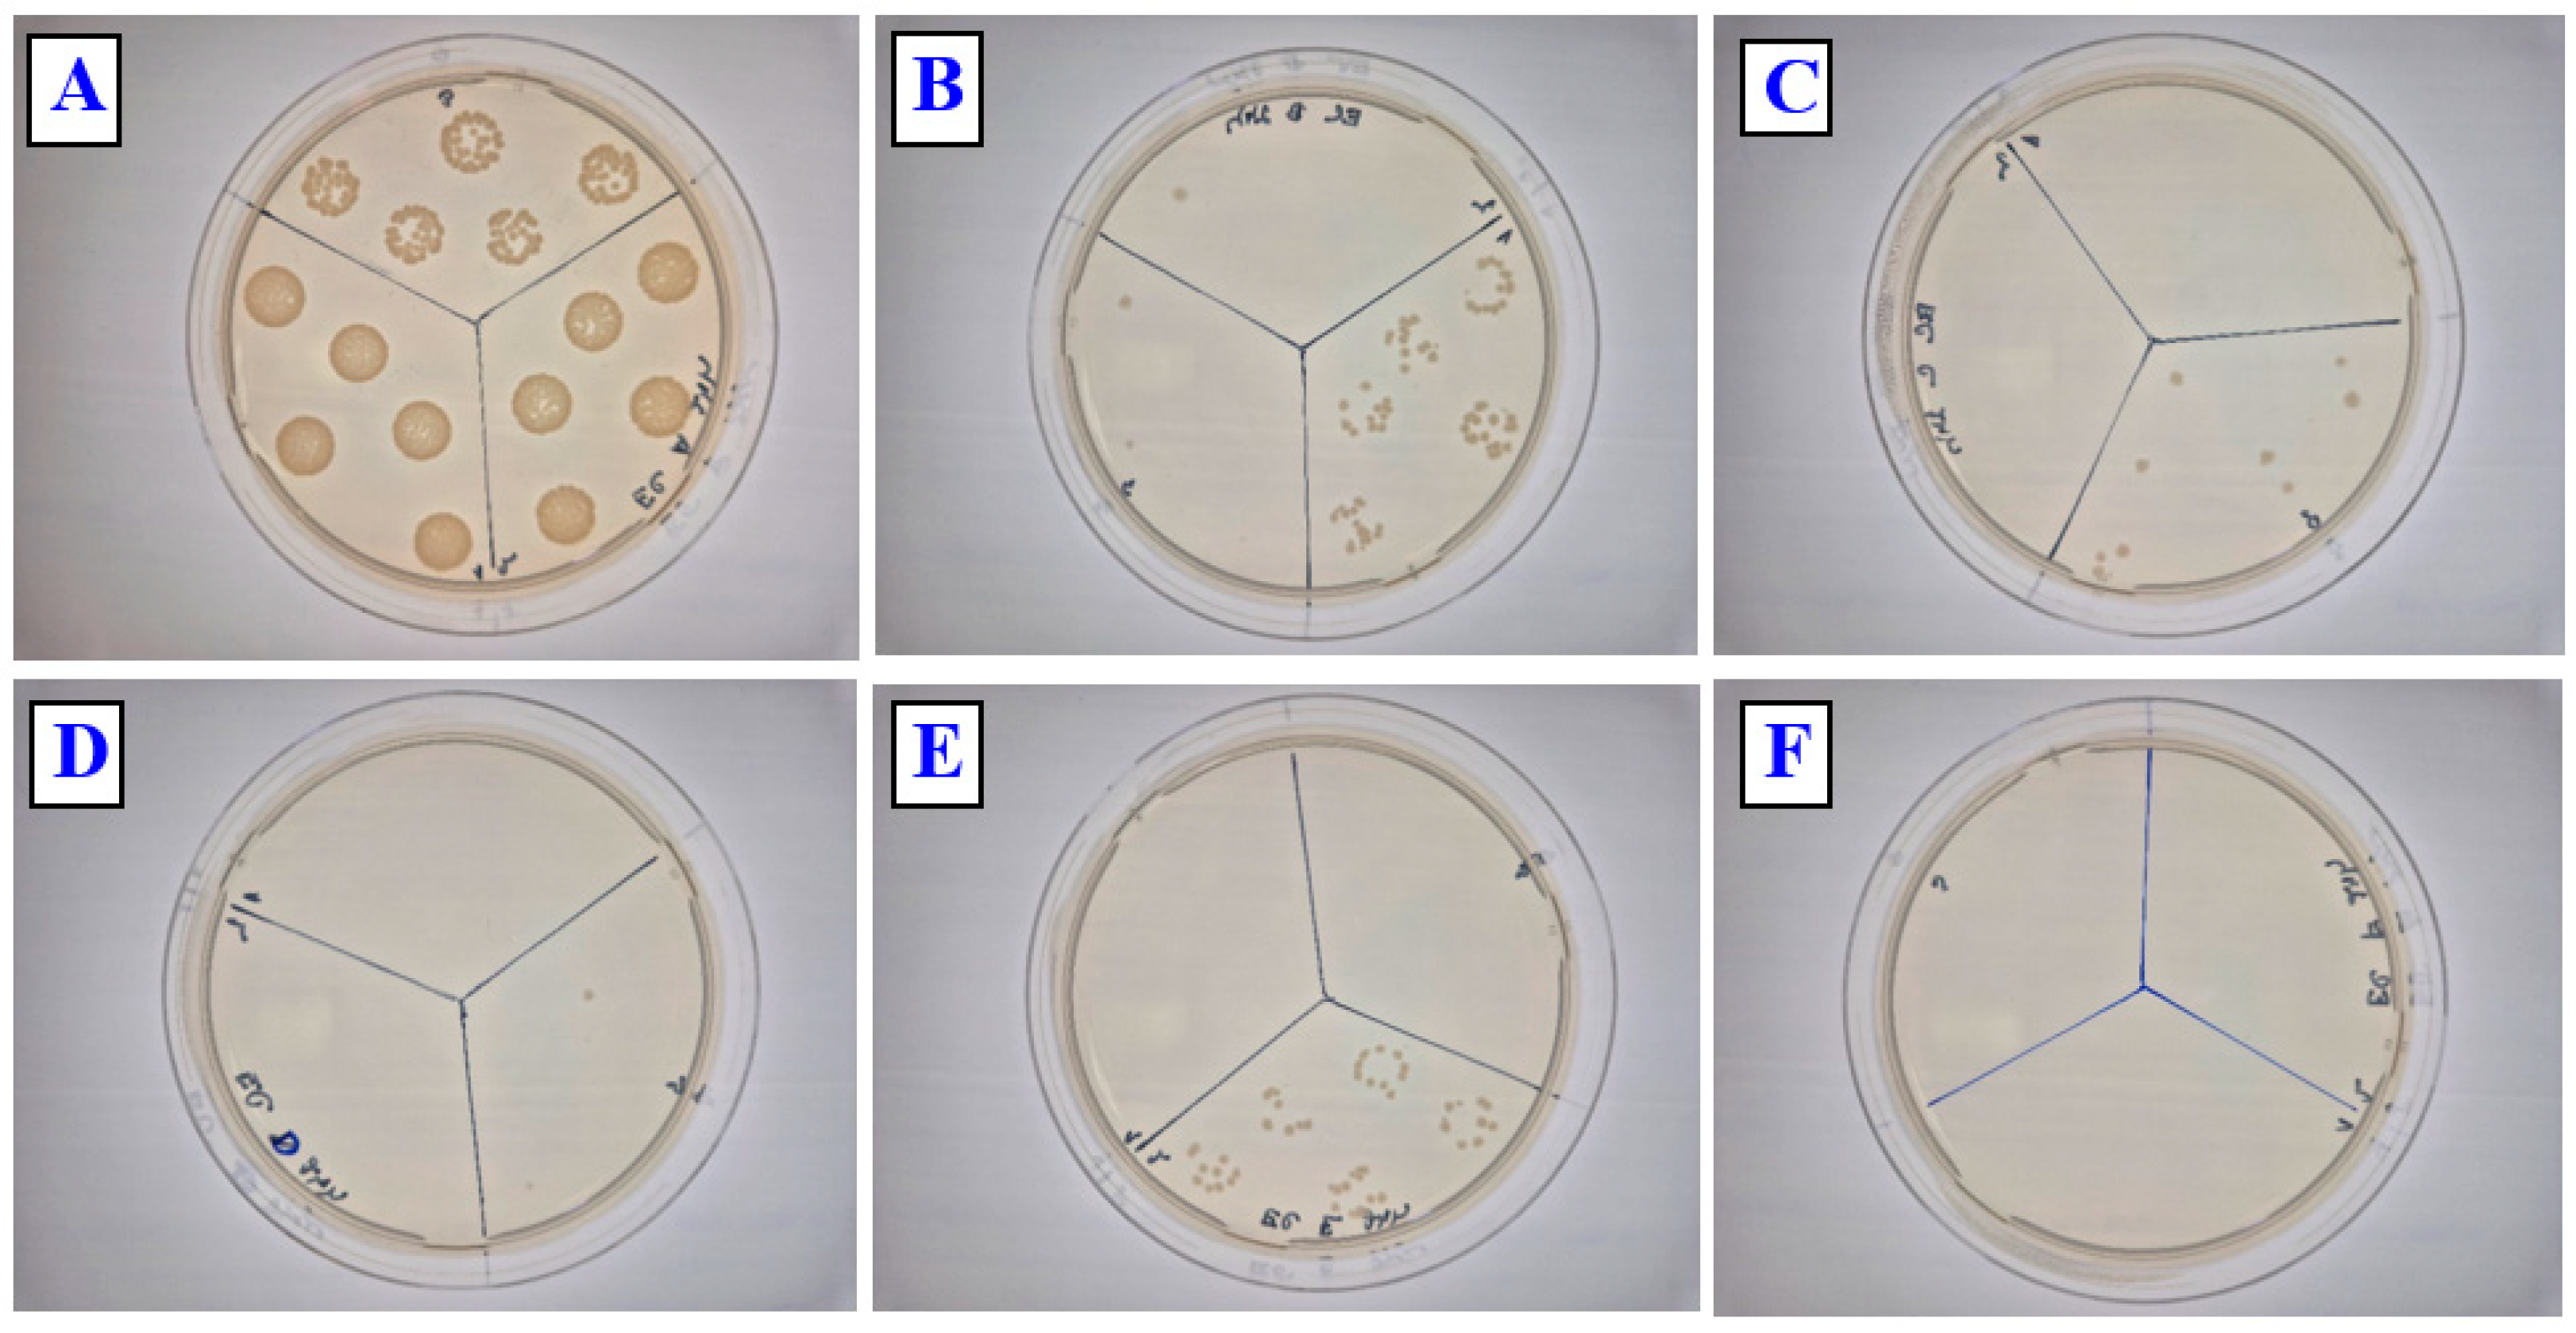
Polymers 17 02173 g012 Polymers 17 02173 g012

Copper–PLLA-Based Biopolymer Wrinkle Structures for Enhanced Antibacterial Activity
Abstract
1. Introduction
2. Materials and Methods
2.1. Materials
2.2. Analytical Methods
2.2.1. Atomic Force Microscopy
2.2.2. Scanning Electron Microscopy
2.2.3. X-Ray Photoelectron Spectrometry
2.2.4. Wettability
2.3. Antibacterial Testing
3. Results
3.1. Atomic Force Microscopy
3.2. Scanning Electron Microscopy and Energy Dispersive Analysis
3.3. X-Ray Photoelectron Spectroscopy
3.4. Wettability
3.5. Antibacterial Properties
4. Conclusions
Supplementary Materials
Author Contributions
Funding
Institutional Review Board Statement
Informed Consent Statement
Data Availability Statement
Conflicts of Interest
References
- Campoccia, D.; Montanaro, L.; Arciola, C.R. A review of the biomaterials technologies for infection-resistant surfaces. Biomaterials 2013, 34, 8533–8554. [Google Scholar] [CrossRef]
- Haq, I.U.; Krukiewicz, K. Antimicrobial approaches for medical implants coating to prevent implants associated infections: Insights to develop durable antimicrobial implants. Appl. Surf. Sci. Adv. 2023, 18, 100532. [Google Scholar] [CrossRef]
- Lee, S.H.; Yoo, S.; Kim, S.H.; Kim, Y.M.; Han, S.I.; Lee, H. Nature-inspired surface modification strategies for implantable devices. Mater. Today Bio 2025, 31, 101615. [Google Scholar] [CrossRef]
- Yadav, K.; Sahu, K.K.; Sucheta, S.; Minz, S.; Raza, W.; Pradhan, M. Microtopographic influence on bacterial biofilm development in habitat-like environments. J. Drug Deliv. Sci. Technol. B 2024, 101, 106311. [Google Scholar] [CrossRef]
- Chen, S.; Wang, Y.; Yang, L.; Chu, C.; Cao, S.; Wang, Z.; Xue, J.; You, Z. Biodegradable elastomers for biomedical applications. Prog. Polym. Sci. 2023, 147, 101763. [Google Scholar] [CrossRef]
- Zhang, S.; Zhang, H.; Sun, J.; Javanmardi, N.; Li, T.; Jin, F.; He, Y.; Zhu, G.; Wang, Y.; Wang, T.; et al. A review of recent advances of piezoelectric poly-L-lactic acid for biomedical applications. Int. J. Biol. Macromol. 2024, 276, 133748. [Google Scholar] [CrossRef]
- Slepička, P.; Neznalová, K.; Fajstavr, D.; Kasálková, N.S.; Švorčík, V. Honeycomb-like pattern formation on perfluoroethylenepropylene enhanced by plasma treatment. Plasma Proc. Polym. 2019, 16, 1900063. [Google Scholar] [CrossRef]
- Neznalová, K.; Fajstavr, D.; Rimpelová, S.; Kasálková, N.S.; Kolská, Z.; Švorčík, V.; Slepička, P. Honeycomb-patterned poly(L-lactic) acid on plasma-activated FEP as cell culture scaffold. Polym. Deg. Stab. 2020, 181, 109370. [Google Scholar] [CrossRef]
- Travnickova, M.; Kasalkova, N.S.; Sedlar, A.; Molitor, M.; Musilkova, J.; Slepicka, P.; Svorcik, V.; Bacakova, L. Differentiation of adipose tissue-derived stem cells towards vascular smooth muscle cells on modified poly(L-lactide) foils. Biomed. Mater. 2021, 16, 025016. [Google Scholar] [CrossRef]
- Slepička, P.; Kasálková, N.S.; Musílková, J.; Bačáková, L.; Frýdlová, B.; Sajdl, P.; Kolská, Z.; Rebollar, E.; Švorčík, V. PLLA honeycombs activated by plasma and high-energy excimer laser for stem cell support. Appl. Surf. Sci. Adv. 2025, 25, 100662. [Google Scholar] [CrossRef]
- Chen, C.-M.; Yang, S. Wrinkling instabilities in polymer films and their applications. Polym. Int. 2012, 61, 1041–1047. [Google Scholar] [CrossRef]
- Yoo, P.J. Fabrication of complexly patterned wavy structures using self-organized anisotropic wrinkling. Electron. Mater. Lett. 2011, 7, 17–23. [Google Scholar] [CrossRef]
- Bowden, N.; Brittain, S.; Evans, A.G.; Hutchinson, J.W.; Whitesides, G.M. Spontaneous formation of ordered structures in thin films of metals supported on an elastomeric polymer. Nature 1998, 393, 146–149. [Google Scholar] [CrossRef]
- Chung, J.Y.; Nolte, A.J.; Stafford, C.M. Diffusion-controlled, self-organized growth of symmetric wrinkling patterns. Adv. Mater. 2009, 21, 1358–1362. [Google Scholar] [CrossRef]
- Efimenko, K.; Rackaitis, M.; Manias, E.; Vaziri, A.; Mahadevan, L.; Genzer, J. Nested self-similar wrinkling patterns in skins. Nat. Mater. 2005, 4, 293–297. [Google Scholar] [CrossRef] [PubMed]
- Ohzono, T.; Shimomura, M. Geometry-dependent stripe rearrangement processes induced by strain on preordered microwrinkle patterns. Langmuir 2005, 21, 7230–7237. [Google Scholar] [CrossRef]
- Yoo, P.J.; Lee, H.H. Morphological diagram for metal/polymer bilayer wrinkling: Influence of thermomechanical properties of polymer layer. Macromolecules 2005, 38, 2820–2831. [Google Scholar] [CrossRef]
- Shugurov, A.R.; Kozelskaya, A.I.; Panin, A.V. Wrinkling of the metal–polymer bilayer: The effect of periodical distribution of stresses and strains. RSC Adv. 2014, 4, 7389–7395. [Google Scholar] [CrossRef]
- Juřík, P.; Slepička, P.; Mistrík, J.; Janíček, P.; Rimpelová, S.; Kolská, Z.; Švorčík, V. Oriented gold ripple-like structures on poly-L-lactic acid. Appl. Surf. Sci. 2014, 321, 503–510. [Google Scholar] [CrossRef]
- Slepička, P.; Juřík, P.; Kolská, Z.; Malinský, P.; Macková, A.; Michaljaničová, I.; Švorčík, V. A novel method for biopolymer surface nanostructuring by platinum deposition and subsequent thermal annealing. Nanoscale Res. Lett. 2012, 7, 671. [Google Scholar] [CrossRef]
- Hassan, I.A.; Parkin, I.P.; Nair, S.P.; Carmalt, C.J. Antimicrobial activity of copper and copper(I) oxide thin films deposited via aerosol-assisted CVD. J. Mater. Chem. B 2014, 2, 2855–2860. [Google Scholar] [CrossRef]
- Ivanova, I.A.; Daskalova, D.S.; Yordanova, L.P.; Pavlova, E.L. Copper and copper nanoparticles applications and their role against infections: A minireview. Processes 2024, 12, 352. [Google Scholar] [CrossRef]
- Crisan, M.C.; Teodora, M.; Lucian, M. Copper nanoparticles: Synthesis, characterization, physiology, toxicity and antimicrobial applications. Appl. Sci. 2022, 12, 141. [Google Scholar] [CrossRef]
- Salah, I.; Parkin, I.P.; Allan, E. Copper as an antimicrobial agent: Recent advances. RSC Adv. 2021, 11, 18179–18186. [Google Scholar] [CrossRef] [PubMed]
- Linda, P.A.; Thakar, R.; Abdul, H.S. The use of copper as an antimicrobial agent in health care, including obstetrics and gynecology. Clin. Microbiol. Rev. 2019, 32, e00125-18. [Google Scholar] [CrossRef] [PubMed]
- Govind, V.; Bharadwaj, S.; Sai Ganesh, M.R.; Vishnu, J.; Shankar, K.V.; Shankar, B.; Rajesh, R. Antiviral properties of copper and its alloys to inactivate covid-19 virus: A review. BioMetals 2021, 34, 1217–1235. [Google Scholar] [CrossRef]
- Li, X.; Wang, Y.; Yin, C.; Yin, Z. Copper nanowires in recent electronic applications: Progress and perspectives. J. Mater. Chem. C 2020, 8, 849–872. [Google Scholar] [CrossRef]
- Abhinav, K.V.; Rao, R.V.K.; Karthik, P.S.; Singh, S.P. Copper conductive inks: Synthesis and utilization in flexible electronics. RSC Adv. 2015, 5, 63985–64030. [Google Scholar] [CrossRef]
- Nguyen, D.H.K.; Bazaka, O.; Bazaka, K.; Crawford, R.J.; Ivanova, E.P. Three-Dimensional Hierarchical Wrinkles on Polymer Films: From Chaotic to Ordered Antimicrobial Topographies. Trends Biotechnol. 2020, 38, 558–571. [Google Scholar] [CrossRef]
- Pellegrino, L.; Kriem, L.S.; Robles, E.S.J.; Cabral, J.T. Microbial Response to Micrometer-Scale Multiaxial Wrinkled Surfaces. ACS Appl. Mater. Interfaces 2022, 14, 31463–31473. [Google Scholar] [CrossRef]
- Khalifa, M.; Lammer, H.; Gadad, M.S.; Varsavas, S.D.; Weng, Z. Recent advances on copper/polymer nanocomposites: Processing strategies, mechanisms, and antibacterial efficacy. Eur. Polym. J. 2025, 223, 113637. [Google Scholar] [CrossRef]
- Manuela, O.; Antunes, W.; Mota, S.; Madureira-Carvalho, Á.; Dinis-Oliveira, R.J.; da Silva, D.D. An Overview of the Recent Advances in Antimicrobial Resistance. Microorganisms 2024, 12, 1920. [Google Scholar] [CrossRef]
- Godoy-Gallardo, M.; Eckhard, U.; Delgado, L.M.; de Roo Puente, Y.J.D.; Hoyos-Nogués, M.; Gil, F.J.; Perez, R.A. Antibacterial approaches in tissue engineering using metal ions and nanoparticles: From mechanisms to applications. Bioact. Mater. 2021, 6, 4470–4490. [Google Scholar] [CrossRef]
- Smola-Dmochowska, A.; Lewicka, K.; Macyk, A.; Rychter, P.; Pamuła, E.; Dobrzyński, P. Biodegradable Polymers and Polymer Composites with Antibacterial Properties. Int. J. Mol. Sci. 2023, 18, 7473. [Google Scholar] [CrossRef] [PubMed]
- Li, D.; Chen, F.; Dong, Z.; Jia, F.; Wen, R.; Sun, C.; Yu, Q. Electrospun PLA/ZnO composite films: Enhanced antibacterial properties and application in fresh chicken meat preservation. Food Packag. Shelf Life 2025, 49, 101536. [Google Scholar] [CrossRef]
- Zhu, G.; Wang, J.; Gao, J.; Lin, X.; Zhu, Z. Simple preparation, big effect: Chitosan-based flame retardant towards simultaneous enhancement of flame retardancy, antibacterial, crystallization and mechanical properties of PLA. Int. J. Biol. Macromol. 2025, 303, 140668. [Google Scholar] [CrossRef]
- Abrari, H.; Ahmadi, T.; Nekouie, V.; Dehaghani, M.T.; Amiri, M.; Razzaghi, M.; Bakhsheshi-Rad, H.R. A study on combination of alkaline treatment and PLA/f-CNTs composite coating on corrosion, biocompatibility and antibacterial activity of Mg alloy. Mater. Today Commun. 2024, 40, 109867. [Google Scholar] [CrossRef]
- Zhao, Y.; Han, Y.; Zhang, H.; Hu, B.; Qu, S.; Miao, C.; Qin, L.; Song, G. The investigation of the photocatalytic degradation and bio-antimicrobial properties based on the biomass carbon dots and the composite nanofiber membranes of biomass carbon dots and PLA. Diamond Rel. Mater. 2025, 158, 112612. [Google Scholar] [CrossRef]
- Lee, H.; Shin, D.Y.; Na, Y.; Han, G.; Kim, J.; Kim, N.; Bang, S.J.; Kang, H.S.; Oh, S.K.; Yoon, C.B.; et al. Antibacterial PLA/Mg composite with enhanced mechanical and biological performance for biodegradable orthopedic implants. Biomater. Adv. 2023, 152, 213523. [Google Scholar] [CrossRef] [PubMed]
- Iqbal, N.; Tan, W.; Zhang, Q.; Iqbal, D.; Hossen, M.I.; Dou, G.; Ning, X.; Ming, J. PLA/AgNPs fiber aerogels and its investigation into their antibacterial properties. J. Mol. Struct. 2024, 1317, 139189. [Google Scholar] [CrossRef]
- Romero, L.M.; Palacio, D.A.; Esquivel, S.; Sanhueza, G.A.S.; Montaño, M.; Rojas, D.; Jaramillo, A.F.; Medina, C.; Montalba, C.; Meléndrez, M.F. Contact antibacterial and biocompatible polymeric, composite with copper zeolite filler and copper oxide, nanoparticles: A step towards new raw materials for the biomedical industry. Polymer 2024, 315, 127795. [Google Scholar] [CrossRef]
- Liu, C.; Wang, D.; Li, Y.; Li, H.; He, L.; Wu, M.; Wei, D.; Pan, H.; Zhao, Y.; Zhang, H. A new strategy for the preparation of polylactic acid composites with UV resistance, light conversion, and antibacterial properties. Int. J. Biol. Macromol. 2024, 278, 135013. [Google Scholar] [CrossRef]
- Salgado, C.D.; Sepkowitz, K.A.; John, J.F.; Cantey, J.R.; Attaway, H.H.; Freeman, K.D.; Sharpe, P.A.; Michels, H.T.; Schmidt, M.G. Copper surfaces reduce the rate of healthcare-acquired infections in the intensive care unit. Infect. Control Hosp. Epidemiol. 2013, 34, 479–486. [Google Scholar] [CrossRef]
- Vincent, M.; Duval, R.E.; Hartemann, P.; Engels-Deutsch, M. Contact killing and antimicrobial properties of copper. J. Appl. Microbiol. 2018, 124, 1032–1046. [Google Scholar] [CrossRef]
- Hasan, J.; Chatterjee, K. Recent advances in engineering topography mediated antibacterial surfaces. Nanoscale 2015, 7, 15568–15575. [Google Scholar] [CrossRef]
- Malinský, P.; Slepička, P.; Hnatowicz, V.; Švorčík, V. Early stages of growth of gold layers sputter deposited on glass and silicon substrates. Nanoscale Res. Lett. 2012, 7, 241–248. [Google Scholar] [CrossRef] [PubMed]
- Li, S.J.; Wu, K.; Yuan, H.Z.; Zhang, J.Y.; Liu, G.; Sun, J. Formation of wrinkled patterns in metal films deposited on elastic substrates: Tunability and wettability. Surf. Coat. Technol. 2019, 362, 35–43. [Google Scholar] [CrossRef]
- Jung, W.B.; Cho, K.M.; Lee, W.K.; Odom, T.W.; Jung, H.T. Universal method for creating hierarchical wrinkles on thin-film surfaces. ACS Appl. Mater. Interfaces 2018, 10, 1347–1355. [Google Scholar] [CrossRef] [PubMed]
- Wang, J.; Do-Quang, M.; Cannon, J.J.; Yue, F.; Suzuki, Y.; Amberg, G.; Shiomi, J. Surface structure determines dynamic wetting. Sci. Rep. 2015, 5, 8474. [Google Scholar] [CrossRef]
- Slepicka, P.; Kasalkova, N.S.; Siegel, J.; Kolska, Z.; Bacakova, L.; Svorcik, V. Nano-structured and functionalized surfaces for cytocompatibility improvement and bactericidal action. Biotechnol. Adv. 2015, 33, 1120–1129. [Google Scholar] [CrossRef] [PubMed]
- Murono, T.; Hongo, K.; Nakano, K.; Maezono, R. Ab-initio-based interface modeling and statistical analysis for estimate of the water contact angle on a metallic Cu(111) surface. Surf. Interfaces 2022, 34, 102342. [Google Scholar] [CrossRef]
- Reznickova, A.; Lacmanova, V.; Kalbacova, M.H.; Hausild, P.; Nohava, J.; Kolska, Z.; Kutova, A.; Slepicka, P. As-deposited and dewetted Cu layers on plasma treated glass: Adhesion study and its effect on biological response. Appl. Surf. Sci. Adv. 2024, 24, 100639. [Google Scholar] [CrossRef]
- Lößlein, S.M.; Merz, R.; Rodríguez-Martínez, Y.; Schäfer, F.; Grützmacher, P.G.; Horwat, D.; Kopnarski, M.; Mücklich, F. Influence of chemistry and topography on the wettability of copper. J. Colloid Interface Sci. 2024, 670, 658–675. [Google Scholar] [CrossRef] [PubMed]
- Zou, Y.; Ross, N.; Nawaj, W.; Borguet, E. A Simplified Approach for Dynamic Contact Angle Measurements. J. Chem. Educ. 2024, 101, 3883–3890. [Google Scholar] [CrossRef]
- van Rooijen, W.; Hashemi, L.; Boon, M.; Farajzadeh, R.; Hajibeygi, H. Microfluidics-based analysis of dynamic contact angles relevant for underground hydrogen storage. Adv. Water Resour. 2022, 164, 104221. [Google Scholar] [CrossRef]
- Grass, G.; Rensing, C.; Solioz, M. Metallic copper as an antimicrobial surface. Appl. Environ. Microbiol. 2011, 77, 1541–1547. [Google Scholar] [CrossRef]
- Lemire, J.A.; Harrison, J.J.; Turner, R.J. Antimicrobial activity of metals: Mechanisms, molecular targets and applications. Nat. Rev. Microbiol. 2013, 11, 371–384. [Google Scholar] [CrossRef]
- Ma, X.; Zhou, S.; Xu, X.; Du, Q. Copper-containing nanoparticles: Mechanism of antimicrobial effect and application in dentistry—A narrative review. Front. Surg. 2022, 9, 905892. [Google Scholar] [CrossRef]

| C [at. %] | O [at. %] | Cu [at. %] | |
|---|---|---|---|
| Pristine PLLA | 62.5 | 37.5 | |
| PLLA + Cu 40 mA 50 s | 40.6 | 41.8 | 17.6 |
| PLLA + Cu 40 mA 50 s + T | 49.7 | 35.5 | 14.8 |
| PLLA + Cu 40 mA 300 s | 38.4 | 35.7 | 26 |
| PLLA + Cu 40 mA 100 s + T | 50.6 | 36.9 | 12.5 |
| PLLA + Cu 40 mA 300 s + T | 50.9 | 34 | 15.1 |
Disclaimer/Publisher’s Note: The statements, opinions and data contained in all publications are solely those of the individual author(s) and contributor(s) and not of MDPI and/or the editor(s). MDPI and/or the editor(s) disclaim responsibility for any injury to people or property resulting from any ideas, methods, instructions or products referred to in the content. |
© 2025 by the authors. Licensee MDPI, Basel, Switzerland. This article is an open access article distributed under the terms and conditions of the Creative Commons Attribution (CC BY) license (https://creativecommons.org/licenses/by/4.0/).
Share and Cite
Slepička, P.; Labíková, I.; Frýdlová, B.; Pagáčová, A.; Slepičková Kasálková, N.; Sajdl, P.; Švorčík, V. Copper–PLLA-Based Biopolymer Wrinkle Structures for Enhanced Antibacterial Activity. Polymers 2025, 17, 2173. https://doi.org/10.3390/polym17162173
Slepička P, Labíková I, Frýdlová B, Pagáčová A, Slepičková Kasálková N, Sajdl P, Švorčík V. Copper–PLLA-Based Biopolymer Wrinkle Structures for Enhanced Antibacterial Activity. Polymers. 2025; 17(16):2173. https://doi.org/10.3390/polym17162173
Chicago/Turabian StyleSlepička, Petr, Iva Labíková, Bára Frýdlová, Aneta Pagáčová, Nikola Slepičková Kasálková, Petr Sajdl, and Václav Švorčík. 2025. "Copper–PLLA-Based Biopolymer Wrinkle Structures for Enhanced Antibacterial Activity" Polymers 17, no. 16: 2173. https://doi.org/10.3390/polym17162173
APA StyleSlepička, P., Labíková, I., Frýdlová, B., Pagáčová, A., Slepičková Kasálková, N., Sajdl, P., & Švorčík, V. (2025). Copper–PLLA-Based Biopolymer Wrinkle Structures for Enhanced Antibacterial Activity. Polymers, 17(16), 2173. https://doi.org/10.3390/polym17162173

